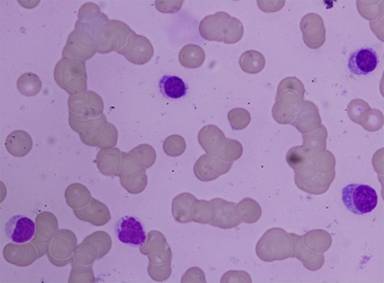

JOP. J Pancreas (Online) 2013 Jan 10; 14(1):92-95.
Waldenstrom Macroglobulinemia Presenting with Pancreatic Mass: A Case Report and Review of Literature
Hemanta Kumar Nayak, Premashish Kar, Avishek Bagchi, Neha Kapoor, Sidarth Kapahtia, Ujjwal Sonika, Naresh Kumar, Suresh Kumar
Department of Medicine, Maulana Azad Medical College, Lok Nayak Hospital. New Delhi, India
ABSTRACT
Context Waldenstrom macroglobulinemia is a rare lymphoplasmacytic lymphoma characterized by a wide range of clinical presentations related to direct tumor infiltration and the production of IgM. Most commonly it presents with cytopenia, hepatosplenomegaly, lymphadenopathy, constitutional symptoms, and hyperviscosity syndrome. Case report We report a case of Waldenstrom macroglobulinemia in an 60-year-old female who initially presented with intermittent abdominal pain. The patient had no peripheral lymphadenopathy. On extensive investigation she was found to have pancreatic mass. The diagnosis of Waldenstrom macroglobulinemia was established after cytomorphology and immunohistochemical analysis of the patient’s bone marrow revealed the presence of a lymphoid/lymphoplasmacytoid-like bone marrow infiltrate along with an elevated serum IgM level. The patient responded both clinically and serologically to chemotherapy. This case is unusual because the patient lacked all common clinical features of Waldenstrom macroglobulinemia with exception of anemia. Conclusion To our knowledge this is the first report of a patient with Waldenstrom macroglobulinemia presenting with a pancreatic mass adding to the spectrum of clinical presentations seen in this disease. This adds to the wide variety of gastrointestinal related clinical presentations of Waldenstrom macroglobulinemia and points to the need for considering Waldenstrom macroglobulinemia along with other lymphoid neoplasms in the differential diagnosis of pancreatic lesions.
INTRODUCTION
Waldenstrom macroglobulinemia is an uncommon B-cell lymphoproliferative neoplasm accounting for only 6% of all B-cell malignancies [1, 2]. Recently it has been considered a unique clinicopathological entity characterized by lymphoplasmacytic bone marrow and tissue infiltrate, as well as the production of serum monoclonal immunoglobulin M (IgM) [1]. This disease has a wide range of clinical presentations with symptoms attributable either to tissue infiltration by neoplastic cells or to the quantity and immunological properties of the monoclonal IgM produced. We report an unusual case of pancreatic mass as the initial presentation of underlying Waldenstrom macroglobulinemia. The diagnosis was based on the presence of a lymphoid/lymphoplasmacytoid bone marrow infiltrate and an elevated serum immunoglobulin M level. This case described the wide variety of gastrointestinal related clinical presentations of Waldenstrom macroglobulinemia and points to the need for considering Waldenstrom macroglobulinemia along with other lymphoid neoplasms in the differential diagnosis of pancreatic lesions.
CASE REPORT
A 60-year-old north-Indian, non-diabetic and non-hypertensive female admitted to Medicine Department with upper abdominal distension and recurrent dull aching epigastric pain for past one month associated with intermittent low grade fever. The pain was localized in epigastrium, constant, dull aching, non-coliky type. It was not radiating to any other site and was not associated with vomiting, diarrhea or other gastrointestinal symptoms .There was no history of jaundice, hematochezia, melena, pedal edema, bleeding from any site. There was no fever, anorexia or weight loss. She did not have any past history of tuberculosis, nor there was any blood transfusion in past.
On examination, the patient was of average build with pallor. There were no significant palpable peripheral lymph nodes or any cutaneous lesions. She was afebrile and hemodynamically stable. Examination of the abdomen showed a firm, smooth epigastric lump (3x3 cm) which was non-tender and non-mobile. There was also mild hepatomegaly but no splenomegaly or ascites. Rest of the abdominal exam was unremarkable. Also, examination of other systems was unremarkable.
Investigations showed the presence of anemia: hemoglobin: 8 g/dL (reference range: 12.1-15.1 g/dL) with normal leukocyte count. erythrocyte sedimentation rate was raised 70 mm in 1st hour by Westergren’s method. Peripheral blood smear was suggestive of macrocytic anemia with thrombocytopenia and few plasmacytoid lymphocytes (Figure 1). Serum iron and vitamin B12 level were within normal range. Serum LDH was within normal limits with negative Coombs test. Liver function tests, renal function tests and blood sugar were within normal limits. She had hyperglobulinemia with altered albumin/globulin ratio (total protein 8.2 g/dL and albumin 2.3 g/dL; reference ranges: 6.0-8.0 g/dL and 3.5-5.0 g/dL, respectively); his total calcium was 10.2 mEq/dL and phosphate was 4.3 mEq/dL. Chest skiagram was normal. Serology for HIV, hepatitis B and hepatitis C was negative. Tuberculin test (Mantoux method) showed an induration of 8 mm.
|
Figure 1. Peripheral blood smear was suggestive of macrocytic anemia with thrombocytopenia and few plasmacytoid lymphocytes. |
Ultrasonography showed mild hepatomegaly and mild ascites with few subcentimetric lymph nodes in periportal, peripancreatic, aortocaval region and a heteroechoic lesion (3.8x2.2 cm) in relation to pancreatic neck region. Ascitic fluid revealed polymorphic picture with low protein (80 cells per 50 high power field, 80% polymorphs and 20% lymphocytes, sugar 97 mg/dL and protein 1.4 g/dL). Adenosine deaminase of ascitic fluid was 19 IU/L. Contrast enhanced computed tomography (CECT) of abdomen revealed mild hepatomegaly, ascites, few subcentimetric lymph nodes in portohepatic and para-aortic region and a well-defined round to oval lesion, anterior to the proximal body of the pancreas (Figure 2). Esophagogastroduodenoscopy was normal, but endoscopic ultrasonogram (EUS) showed an irregular, predominantly hypoechoic heterogeneous mass in relation to body of pancreas without any invasion into portal vein or aorta. Endoscopy guided fine needle aspiration cytology was suggestive of multiple atypical lymphocytes (Figure 3). Immunohistochemical staining of these cells was positive for CD20, CD79a, and negative for CD5, CD43, and CD23.
On further investigation there was a sharp M band in the gamma-globulin region detected on serum protein electrophoresis (Figure 4). Hematological and immunologic workup revealed an elevated IgM serum level of 3,123 mg/dL. However, urine was negative for Bence Jones protein.

|
Figure 2. Contrast enhanced computed tomography (CECT) of abdomen revealed mild hepatomegaly, ascites, few subcentimetric lymph nodes in portohepatic and para-aortic region and a well-defined round to oval lesion, anterior to the proximal body of pancreas. |

|
Figure 3. Endoscopy guided fine needle aspiration cytology was suggestive of multiple atypical lymphocytes. |

|
Figure 4. Serum electrophoresis. There was a sharp M band in the gamma-globulin region detected on serum protein electrophoresis (Patient #811). |
On bone marrow aspiration, marrow was infiltrated by lymphoplasmacytoid cells, constituting 50% of marrow nucleated cells (Figure 5). Bone marrow biopsy revealed hypercellular marrow replaced by sheets of lymphoplasmacytoid cells scattered amongst lymphoplasmacytic cells and few plasma cells. Immunohistochemical staining of these cells was positive for CD20, CD79a, partially positive for CD10, and negative for CD5, CD43, and CD23 (Figure 6). Skeletal survey was advised which was essentially normal study with no evidence of any osteolytic bony lesions or diffuse osteopenia.

|
Figure 5. Marrow was infiltrated by lymphoplasmacytoid cells on bone marrow aspiration. |

|
Figure 6. Immunohistochemical staining of these cells was positive for CD20 and partially for CD10, negative for CD5, CD43, and CD23. |
A final diagnosis of Waldenstrom macroglobulinemia with extramedullary (peripancreatic) involvement was made. Her anemia was corrected by blood transfusion and hematinics. The patient was started on dexamethasone, rituximab and cyclophosphamide regimen consisting of 20 mg of dexamethasone administered intravenously followed by rituximab intravenously at 375 mg/m2 on day 1 and cyclophosphamide orally at 100 mg/m2 twice daily on days 1 to 5 every 21 days. She has received three such cycles and her recent ultrasound has shown a decrease in the size (1.6x1.4 cm) of the mass and her serum IgM level has gradually dropped to 1,267 mg/dL and also she improved her anemia and thrombocytopenia. A repeat CECT and bone marrow aspiration are planned after six cycles of chemotherapy.
DISCUSSION
The World Health Organization defines Waldenstrom macroglobulinemia as a lymphoplasmacytic lymphoma associated with a monoclonal immunoglobulin M (IgM) protein [1]. In the original description of Waldenstrom macroglobulinemia, Waldenstrom described two patients with oronasal bleeding, lymphadenopathy, anemia, thrombocytopenia, and an elevated sedimentation rate [2]. The disorder is a lymphoplasmacytic lymphoma with a monoclonal pentameric IgM protein [3]. Bone marrow and lymph nodes are infiltrated with pleomorphic B-lineage cells at different stages of maturation [4]. The bone marrow pattern is predominantly inter-trabecular and is considered lymphoplasmacytic lymphoma by the World Health Organization [1]. Most patients who fulfill all other criteria for the diagnosis have a presymptomatic phase and may not require therapy [5]. The cells express pan B-cell markers (e.g., CD19 and CD20) and typically test negative for CD3 and CD103 [6].
The clinical manifestations of the disorder are hepatomegaly (20%), splenomegaly (15%), and lymphadenopathy (15%) [7]. The most common presenting symptom is fatigue related to a normochromic or normocytic anemia. The median hemoglobin value at diagnosis is 10 g/dL [8]. The circulation, tissue deposition, and autoimmune properties of IgM monoclonal proteins are responsible for an array of clinical manifestations in Waldenstrom macroglobulinemia. Hyperviscosity is one of the most characteristic features of Waldenstrom macroglobulinemia; however, it is seen in only 15% of cases and is clinically characterized by oronasal hemorrhage, visual defects, and multiple neurological abnormalities [9, 10]. Other presenting symptoms related to monoclonal IgM include cryoglobulinemia and cold agglutinin hemolytic anemia occurring in 5% of patients, peripheral neuropathies in 5-10% and amyloidosis in 2% [11, 12]. Extramedullary involvement occurs in a subset of patients and is infrequently examined histologically. Pei Lin et al. has studied 44 extramedullary sites of Waldenstrom macroglobulinemia and has found a total of 51 specimens obtained from lymph nodes (n=36), soft tissue (n=4), spleen (n=3), skin (n=2), lung (n=2), tonsils (n=1), colon (n=1), liver (n=1), and gallbladder (n=1) and lymphoplasmacytic lymphoma was the most common histological type, in 40 (78%) samples [13]. Waldenstrom macroglobulinemia has known gastrointestinal involvement with stomach being the most common site [14, 15]. Though pancreatic involvement in multiple myeloma is a known entity and there are no reports in literature regarding of pancreatic involvement in Waldenstrom macroglobulinemia [16].
The reported case here described Waldenstrom macroglobulinemia presenting with a peripancreatic mass and its response to chemotherapy. The diagnosis of Waldenstrom macroglobulinemia was made based on the presence of inter- trabecular bone marrow infiltration by atypical lymphocytes showing plasma cell and plasmacytoid differentiation along with elevated serum IgM. Waldenstrom macroglobulinemia was considered the cause of the pancreatic mass consisted of an infiltrate similar to that found in the bone marrow. This case is unusual, since the patient lacked all the common clinical features of Waldenstrom macroglobulinemia except the fact that the patient was anemic. The patient responded well to standard chemotherapeutic regimen.
Although rare, Waldenstrom macroglobulinemia presenting as mass lesion have been described in the literature. But, to our knowledge this is the first report of a patient with Waldenstrom macroglobulinemia presenting with a pancreatic mass. This adds to the wide variety of gastrointestinal related clinical presentations of Waldenstrom macroglobulinemia and points to the need for considering Waldenstrom macroglobulinemia along with other lymphoid neoplasms in the differential diagnosis of pancreatic lesions.
Received October 27th, 2012 – Accepted November 27th, 2012
Key words Pancreatic Neoplasms, Waldenstrom Macroglobulinemia
Competing interests None
Correspondence
Hemanta
Kumar Nayak
Lok Nayak Hospital
Maulana Azad Medical College
New Delhi
India
Phone: +91-783.880.1553
Fax: + 91-11.2323.2424
E-mail: drhemantnayak@gmail.com
References
1. Owen RG, Treon SP, Al-Katib A, et al. Clinicopathological definition of Waldenstrom’s macroglobulinemia: Consensus panel recommendations from the Second International Workshop on Waldenstrom’s macroglobulinemia. SeminOncol 2003; 30:110–115.
2. Waldenstrom J. Macroglobulinaemia. Acta Haematol 1958;20:33–39.
3. Vitolo U, Ferreri AJ, Montoto S. Lymphoplasmacytic lymphoma-Waldenstrom’s macroglobulinemia. Crit Rev Oncol Hematol 2008;67:172–185.
4. Pangalis GA, Angelopoulou MK, Vassilakopoulos TP, et al. B-chronic lymphocytic leukemia, small lymphocytic lymphoma, and lymphoplasmacytic lymphoma, including Waldenstrom’s macroglobulinemia: A clinical, morphologic,and biologic spectrum of similar disorders. Semin Hematol 1999;36:104–114.
5. Kyle RA, Benson J, Larson D, et al. IgM monoclonal gammopathy of undetermined significance and smoldering Waldenstro¨m’s macroglobulinemia. Clin Lymph Myeloma 2009;9:17–18
6. Morice WG, Chen D, Kurtin PJ, et al. Novel immunophenotypic features of marrow lymphoplasmacytic lymphoma and correlation with Waldenstrom’s macroglobulinemia. Mod Pathol 2009;22:807–816.
7. Dimopoulos MA, Anagnostopoulos A. Waldenstro¨m’s macroglobulinemia. Best Pract Res Clin Haematol 2005;18: 747–765.
8. Bjorkholm M, Johansson E, Papamichael D, et al. Patterns of clinical presentation, treatment, and outcome in patients with Waldenstrom’s macroglobulinemia:A two-institution study. Semin Oncol 2003;30:226–230.
9. Alexanian R. Blood volume in monoclonal gammopathy. Blood 1977;49: 301–307.
10. Kwaan HC, Bongu A. The hyperviscosity syndromes. Semin Thromb Hemost 1999;25:199–208.
11. Vital A. Paraproteinemic neuropathies. Brain Pathol 2001;11:399–407.
12. Gertz MA, Kyle RA, Noel P. Primary systemic amyloidosis: A rare complication of immunoglobulin M monoclonal gammopathies and Waldenstrom’s macroglobulinemia. J Clin Oncol 1993;11:914–920.
13. Pei Lin, M.D., Carlos Bueso-Ramos, M.D., Ph.D.,Carla S. Wilson, M.D., Ph.D., Adnan Mansoor, M.D., and L. Jeffrey Medeiros, M.D; The American Journal of Surgical Pathology 27(8): 1104–1113, 2003
14. Froget J, Pergola F, Cachin M. Gastric localization of Waldenström's disease]. Ann Gastroenterol Hepatol (Paris). 1972 Jul-Sep;8(4):311-6
15. Solignac H, Castany J, Barthélemy Y, Desmonts T, Liautier N.; Waldenström's macroglobulinemia. Revealing pseudotumoral gastric localization.Nouv Presse Med. 1972 Mar 11;1(11):729-32.
16. Gupta P, Rice GD, Abraham K, Ghole V, Ketkar M. Extramedullary plasmacytoma of the pancreas and jejunum. Clin Imaging. 2009 May-Jun;33(3):240-3.